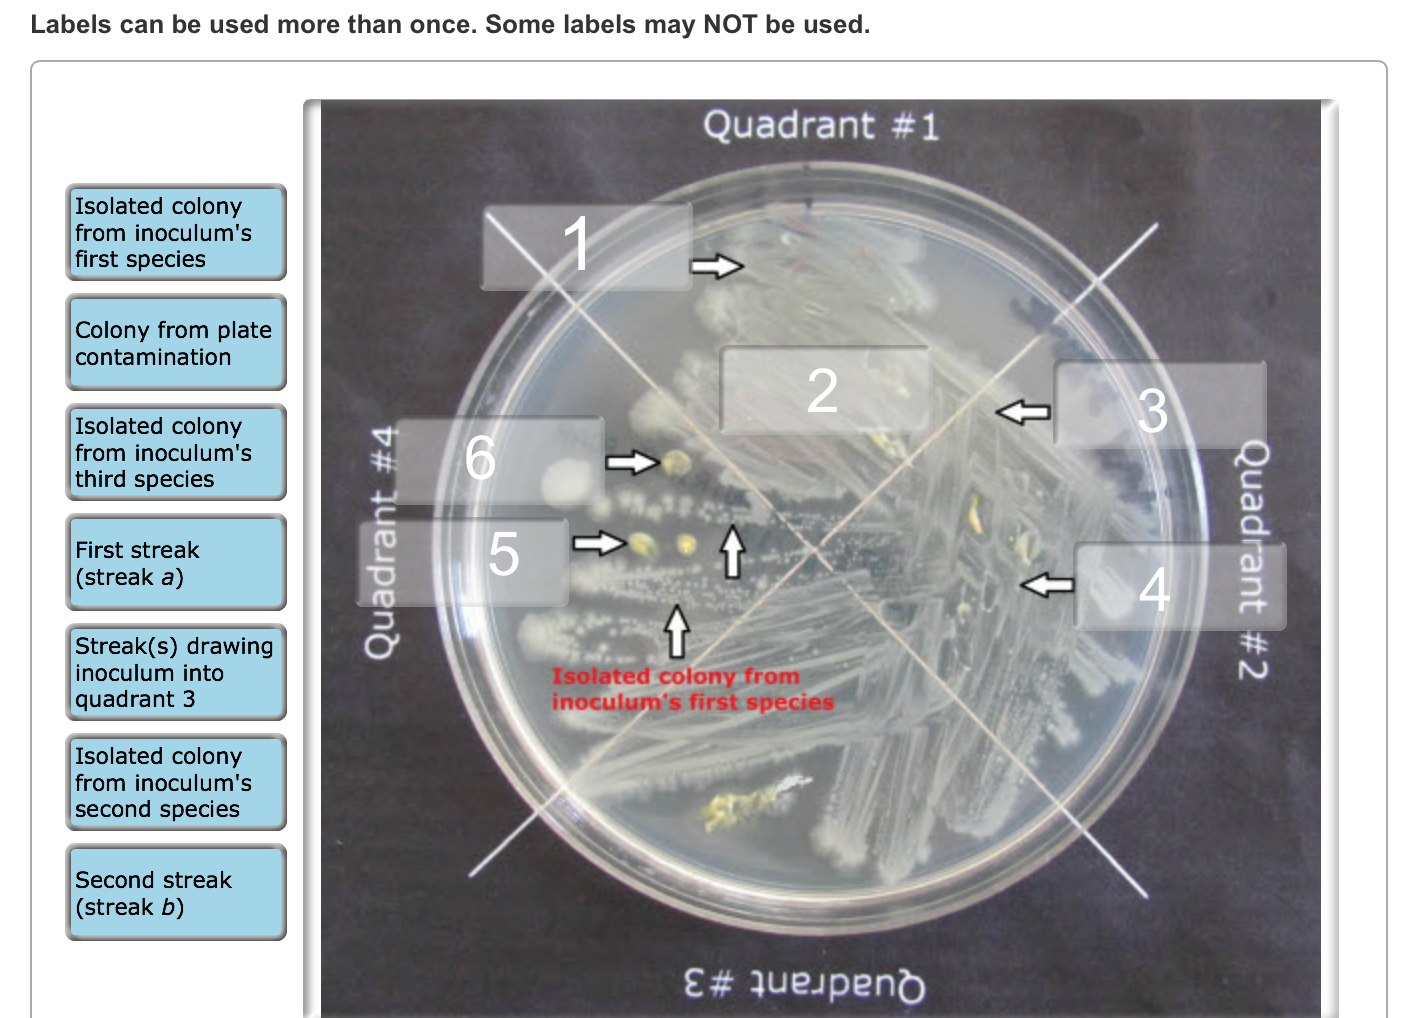

38 chegg rental coupon code
Chegg promo codes and coupons | April 2022 - Promocodes.com Save $8 on average with Chegg promo codes and coupons for April 2022. Find 2 Chegg coupons and discounts at Promocodes.com. Tested and verified on Apr 18, 2022. ... and the site plants a tree for every book rented, bought, or sold. In addition to textbook rentals, Chegg.com offers the option to buy your books and will buy your textbooks for ... deals.usnews.com › coupons › chegg90% Off Chegg Coupon for May 2022 - U.S. News & World Report Free Shipping with Chegg discount code on on Textbook Rental Or Sale. Choose the subscription that sUpports your need. Enjoy free delivery on your book rentals or Purchases today. Minimum required. $35+. More details. 90% off Chegg Textbooks. 90% Offer. Expiring 12/30/2022.
30% Off Chegg Coupons & Deals May 2022 - 10% Off Code Today's Chegg Top Offers 90% Off On Textbooks2 Total Offers 7 Coupon Codes 0 Free Shipping Deals 0 Special Deals 6 Best Discount 90% About Chegg Chegg is a network which is backed up by the help of humans. It is personalized, on demand and adaptive.

Chegg rental coupon code
› coupons › chegg40% Off Chegg Coupons & Promo Codes - June 2022 25% Off Chegg Coupons & Promo Codes - June 2022 You've earned $0 in cashback . Sign up to activate! Chegg Coupons, Promo Codes and Cash Back 6 Verified Coupons for June 01, 2022 Earn up to 50% Cash Back at Chegg No expiration Sign Up CODE ON SALE Coupon Code for Free Shipping on Orders Over $35 expires: ongoing Chegg Coupons 2022 | 10% off - 60% off Chegg Coupon Codes, Deals ... Save up to 10% off - 60% off off with Chegg Coupon Codes , Discount Codes. Enjoy free valid Chegg Coupons & Promo Codes now! 100% verified. 13,575,244 vouchers for 32,837 stores, Updated on May 09,22. Search. All Categories. Automotive; Baby & Kids ... Up to 90% off rent textbooks. Move to chegg.com for purchase at reduced prices. Get it today ... Chegg Coupons - 25% OFF in June 2022 Get Chegg coupon codes for 90% OFF in June 2022 All (10) Online Coupons (2) Deals (8) Free delivery (1) Best Coupon 25% OFF Students Get 25% Off First Month Subscription With Chegg Coupon through...
Chegg rental coupon code. Chegg Coupon | Chegg.com Chegg Coupon Coupons from Chegg are currently not available. Check back soon for Chegg coupon codes! Looking for a Chegg coupon? Check back soon! Many online sites offer Chegg coupons or discount codes, but at Chegg you'll always find the latest and greatest coupons. Solved Videobusters, Incorporated offered books of video - Chegg Question: Videobusters, Incorporated offered books of video rental coupons to its patrons at $34 per book. Each book contained a certain number of coupons for video rentals. During the current period 440 books were sold for $14,960, and this amount was credited to Unearned Rental Revenue. At the end of the period, it was determined that Ș12 ... 30% Off | Chegg Coupons | March 2022 Chegg student discount. There is a Chegg student discount: Students receive 30 days of Chegg Study for free. The program provides in-depth explanations of how to do math problems, written assignments, and more. After the free 30 days, it's $14.95 a month. Students can also take advantage of Chegg promotions or use coupons. › view › cheggChegg Coupons: Coupon Codes, Promos 2022 - RetailMeNot.com Find {couponCount} Chegg coupons and coupon codes for June 2022 on RetailMeNot."}} Today's top Chegg coupon: $10 Off Your Order. Find 25 Chegg promo and coupon codes for June 2022 on RetailMeNot.
25% Off In June 2022 | Chegg Coupons | SFGate Other offers include a Chegg free trial, massive discounts off rentals of Chegg textbooks, Chegg Study coupon opportunities, Chegg student discount codes for $100 off book orders, and many others. Chegg Coupon, Chegg Coupon Code & Chegg discount code SmartsSaving Chegg coupon, Chegg coupon code and Chegg discount code. Exclusive Chegg promo code from SmartsSaving. When you buy a product or service through links on SmartsSaving.com, we may earn a commission. ... Save up to 90% when you rent. Will Expire on: Dec 31, 2022 365 Times Used Verified Coupon . Free Shipping Orders Over $35. › coupons › cheggChegg Coupons | 25% Off In June 2022 | Forbes Apply this Chegg promo code for 20% off book rentals, or purchases for a limited time only. 20% OFF 1 use today Chegg coupon: 25% off + free shipping for a limited time Gear up for the new school... Chegg Coupons | Up to 60% Discount Offers | Jun 2022 Get Latest Chegg Coupons, Coupon Codes, Promotional Offers, Discount Deals, Vouchers, Promo Code To Avail The Up to 60% OFF on your Orders ... Buy & Get Free 4-Week Trial Of Chegg Study With Textbook Purchase or Rental. Offer Is Valid For All Users. No Coupon Code Required At Checkout. At $14.95/Month OFF. COUPON. At $14.95/Month
coupons.cnet.com › coupons › chegg30% Off – Chegg Coupons – June 2022 Jun 01, 2022 · All Valid Chegg Discount Codes & Offers in June 2022. DISCOUNT. Chegg COUPON INFORMATION. Expiration Date. 30%. Save Big: 30% off. Currently, there is no expiration date. 30%. Save Big: 30% off. couponfollow.com › site › cheggChegg Coupon Codes 2022 (60% discount) - June Promo Codes Chegg Coupon Codes 2022 (60% discount) - May Promo Codes Chegg Coupon Codes. chegg.com 60% OFF COUPON CODE Save 60% Off w/ Coupon Code Score 60% off with coupon IVE Show Coupon Code in Chegg coupons 25% OFF COUPON CODE Save 25% Off Sitewide Save 25% on Your Entire Order JC3 Show Coupon Code in Chegg coupons Never miss a coupon! 50% Off Chegg Coupons & Promo Codes | June 2022 Save up to 50% off with our best Chegg coupon. Get 50% Off On Chegg Study Pack Subscription with code CHEGGXSE. Highest ever Chegg discount: Take $248.21 Off On The Economics Today 18th Edition. Latest Chegg Offer: Save Up To 90% On Textbooks1. Our coupons save shoppers an average of $45 at Chegg. On average we discover a new Chegg discount ... Chegg Coupons For Free Trial (May 2022) - Zouton Chegg Free Trial Coupon Details: Redeem this offer on Book purchases or rentals. Add the desired books to your cart: Select the "Add 4 weeks free" option. Charges of $14.95/month will be applicable after the free trial ends. Chegg coupon code is not required to avail this offer. There is no minimum order value requirement.
30% Chegg Discount | May 2022 - Boston.com Coupons Expired Chegg coupons and promo codes. Sometimes these Chegg coupons still work after they expire. $25. COUPON. Editor Pick: $25 off with Promo Code. Use Coupon. Terms & Conditions. 20%. COUPON.
Chegg Coupons and Promo Codes (Jan 2020) : Direct Textbook Chegg coupons codes. Up to 16% off Chegg Rentals. Free Chegg Study Trial.
Chegg ($10 Off Coupon) & Coupon Codes Jun 2022 - Slickdeals Chegg Coupons and Promo Codes | June 2022 CODE Coupon Free Shipping With This Coupon Coupon Verified! 3 Used Today Get Coupon Code 90% off Sale Up to 90% Off Textbooks + Free Shipping Over $30+ Offer Verified!1 used today Get Offer $10 off Coupon Save $10 Off With This Promo Code Coupon Verified! 12 Used Today Get Coupon Code SALE Sale
Chegg Free Trial May 2022: Up to 90% Reduction Chegg Top Coupon Codes and Offers. Chegg Free Trial. 25% Off + Free Standard Shipping On Orders Of $50 Or More. Free Standard Shipping On $45 Or More Physical Textbook Rental Or Buy At Chegg. Get A 4-week Chegg Study Free Trial. Add This 30% Off Promo Code To Your Next Chegg Order.
› coupons › chegg$5 Off Chegg Coupons & Coupon Codes | June 2022 - Groupon Coupon Code $5 Off Your 1st Month (Chegg Coupon Code) Subscribe to Chegg today, & get $5 off your first month! Use this Chegg coupon code to save today. qzk See Code 60 used Free Trial Promo Save On The New Semester With A Chegg Free Trial Spring semester is right around the corner!
Chegg Coupons | Jun 2022 | Verified Chegg Coupons and Discount Codes For June 2022 - View all the best discount codes and coupons for Chegg. ... Up To 90% Off At Chegg. Rent Textbooks & Get 7-Day Free Instant Access. Free Shipping on Orders $35+ Get a 4 week free trial of Chegg Study with your Textbook Rental! Save Money on Textbooks. Rent or Buy. Free Returns. Services: Textbook ...
5 Best Chegg Coupons, Promo Codes + 90% Off - Mar 2022 - Honey Car Rental; Books; Beauty / Cosmetics; Coupon Codes Total Offers; 5: 13: FAQ's. ... Chegg Coupon Code - Last worked 11 minutes ago: FAAH483D: Last Saved $9.97: Promo Code for Chegg - Last saved $9.97: CHEGG22: Last Saved $0.14: Chegg Coupon Code - Last worked 2 days ago: Home > Chegg. Company. About Help Careers News Blog Media.
Chegg Coupons/ Free Trial - June 2022 - Super Easy Chegg has coupon codes. You can use Chegg coupons to enjoy extra discounts, free shipping and other offers. If you're tired of searching and just want the latest working code asap, you should definitely try Coupert. It's a powerful browser extension that helps you hunt and verify promo codes automatically and get cashback on every order.
Chegg Coupons - 25% OFF in June 2022 Get Chegg coupon codes for 90% OFF in June 2022 All (10) Online Coupons (2) Deals (8) Free delivery (1) Best Coupon 25% OFF Students Get 25% Off First Month Subscription With Chegg Coupon through...
Chegg Coupons 2022 | 10% off - 60% off Chegg Coupon Codes, Deals ... Save up to 10% off - 60% off off with Chegg Coupon Codes , Discount Codes. Enjoy free valid Chegg Coupons & Promo Codes now! 100% verified. 13,575,244 vouchers for 32,837 stores, Updated on May 09,22. Search. All Categories. Automotive; Baby & Kids ... Up to 90% off rent textbooks. Move to chegg.com for purchase at reduced prices. Get it today ...
› coupons › chegg40% Off Chegg Coupons & Promo Codes - June 2022 25% Off Chegg Coupons & Promo Codes - June 2022 You've earned $0 in cashback . Sign up to activate! Chegg Coupons, Promo Codes and Cash Back 6 Verified Coupons for June 01, 2022 Earn up to 50% Cash Back at Chegg No expiration Sign Up CODE ON SALE Coupon Code for Free Shipping on Orders Over $35 expires: ongoing

Post a Comment for "38 chegg rental coupon code"